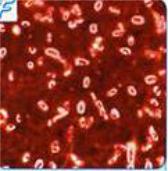

Материал: Строение_бактериальной_клетки

ДВИЖЕНИЕ БАКТЕРИЙ
движение бактерий связано с наличием жгутиков жгутики представляют собой спирально закрученные нити, состоящие из
специфического белка флагеллина, который по своей структуре относится к сократительным белкам типа миозина.
классификация бактерий по количеству и расположению жгутиков
строение бактериального жгутика
методы выявления подвижности бактерий
ПРЯМЫЕ
КОСВЕННЫЕ
1. электронная микроскопия 1. препараты «висячей» и «раздавленной» капли
2. окраска жгутиков |
2. темнопольная микроскопия |

3. посев уколом в полужидкий агар (демонстрация)

КАПСУЛООБРАЗОВАНИЕ У БАКТЕРИЙ
Капсула бактерий – это утолщенный наружный слой клеточной стенки. Капсулы могут содержать полисахариды (пневмококк) или белки (возбудитель сибирской язвы), но основным компонентом капсулы (до 70%) является вода. Большинство бактерий, особенно патогенных, образует капсулу только в организме человека или животных. Некоторые бактерии могут иметь микрокапсулу (выявляется только при электронной микроскопии), например, кишечные палочки, золотистые стафилококки, менингококки.
Основное предназначение капсул – защита бактерий от фагоцитоза.
СХЕМА ОКРАСКИ ПО ГИНС - БУРРИ
капсулы бактерий при окраске по Гинс-Бурри
капсулы бактерий при окраске по Гинс-Бурри

